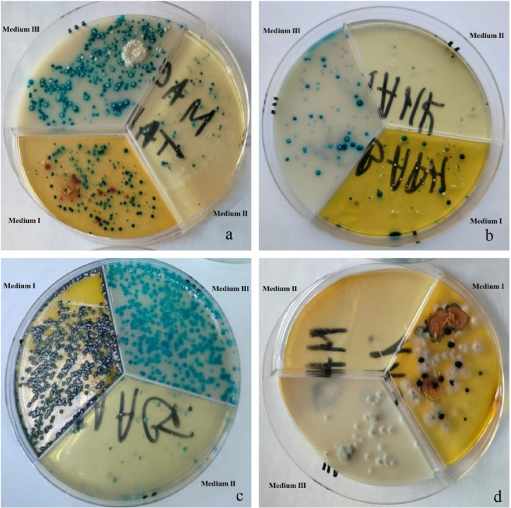

Scroll to:
Development and testing of a set of chromogenic media for rapid diagnosis of bovine mastitis
https://doi.org/10.29326/2304-196X-2025-14-2-171-178
Abstract
Introduction. Bovine mastitis remains one of the most prevalent and economically significant diseases in dairy cattle production. Three chromogenic media have been proposed for the diagnosis, each specifically designed for isolation and differentiation of certain mastitis pathogen groups: Medium I is intended for Enterobacteriaceae family bacteria, Medium II – for Staphylococcus genus microorganisms, Medium III – for Streptococcus genus bacteria.
Objective. The objective is to evaluate the sensitivity, specificity, differentiation capacities and inhibitory properties of these chromogenic media, and to test the media using milk samples from mastitic cows.
Materials and methods. For sensitivity testing, the control strains (Streptococcus agalactiae, Staphylococcus aureus and Escherichia coli) at concentrations of 1×100, 1×101, and 1×102 CFU/mL were used. Microbial growth was assessed following 24-hour incubation at 37 °C. Specificity and differentiation capacities were studied using 22 microbial strains, their growth patterns and colony coloration in chromogenic and control media were compared. Inhibitory properties were determined based on presence/absence of culture growth. The media were evaluated using milk samples from mastitic cows and standardized culturing methods.
Results. The chromogenic media demonstrated sensitivity comparable to the control media (Columbia agar supplemented with 5% defibrinated sheep blood), p > 0.05. Medium I enabled reliable color-based differentiation but showed limited inhibitory effects. Medium II ensured selective isolation of staphylococci while effectively suppressing growth of other bacteria. Medium III supported growth of both enterococci and streptococci, including Streptococcus agalactiae. The tests conducted in milk samples confirmed genus level differentiation capability.
Conclusion. The developed chromogenic media ensure high-accuracy mastitis diagnosis due to their sensitivity, specificity and differentiation properties. Their implementation makes it possible to cover an extensive range of microorganisms and to selectively isolate the targeted bacterial groups. Further work will be aimed at improving the media for fungal growth suppression and increasing the diagnostic accuracy.
For citations:
Kapustin A.V., Laishevtsev A.I., Savinov V.A., Shastin P.N., Gilmanov Kh.Kh., Khabarova A.V. Development and testing of a set of chromogenic media for rapid diagnosis of bovine mastitis. Veterinary Science Today. 2025;14(2):171-178. https://doi.org/10.29326/2304-196X-2025-14-2-171-178
INTRODUCTION
Bovine mastitis, an inflammatory condition of the mammary gland, ranks among the most widespread and economically impactful diseases in dairy production [1-3]. Transmission occurs due to multiple factors, including poor milking hygiene, suboptimal housing conditions, improper milking techniques, weakened animal immunity and inadequate preventive measures [4-6]. The disease presents in both clinical form – characterized by visible symptoms such as udder swelling, redness, and pain – and subclinical form, which lacks overt inflammation but results in reduced milk quality [7].
The etiology of mastitis comprises two primary causative groups: mechanical and infectious. Mechanical causes involve udder injuries resulting from inappropriate milking techniques, defective milking equipment or traumas during grazing. These injuries establish favorable conditions for microbial invasion, potentially leading to inflammatory development [8]. Nevertheless, pathogenic microorganisms constitute the principal factor in mastitis occurrence [9].
The most common pathogens of mastitis are Staphylococcus aureus, Streptococcus agalactiae, Escherichia coli and others [10, 11]. S. aureus is one of the most dangerous pathogens, as it can induce chronic forms of mastitis that are resistant to treatment [12-15]. S. agalactiae is transmitted mainly through milking equipment and can persist in cows for a long time [16]. E. coli often causes acute forms of mastitis, accompanied by severe symptoms [17].
To diagnose infectious bovine mastitis, veterinarians have multiple diagnostic tools at their disposal, each tool having its distinct advantages and limitations [18-24]. Among these, bacteriological milk testing remains one of the most widely used methods [25][26]. This procedure involves aseptic milk sample collection followed by inoculation onto culture media. After thermostat incubation, microorganisms are identified based on their morphological, biochemical and cultural properties. While this method enables precise pathogen identification and facilitates targeted treatment selection, it requires specialized equipment and has a relatively long turnaround time (2–3 days) [27]. Chromogenic media can be used to speed up the diagnosis of infectious mastitis. These specialized media contain substrates that undergo color changes when acted upon by pathogen-specific enzymes, allowing for etiological agent identification within 24 hours post-inoculation. Current rapid test options include Compact Dry (R-Biopharm AG, Germany) and RIDA® COUNT (Chisso Corporation, Japan) test plates [28, 29]. These test systems feature various specialized assays for determining S. aureus, Enterobacteriaceae, Salmonella, total microbial count, E. coli, as well as yeast and mold contamination.
The Laboratory for Diagnostics and Control of Antibiotic Resistance of Pathogens of the Most Clinically Significant Infectious Animal Diseases, Federal Scientific Centre VIEV has developed its own formulation of chromogenic media for differentiating mastitis pathogens without requiring lengthy laboratory studies. The set consists of three distinct chromogenic media that, when used together, enable identification of the mastitis pathogen spectrum in each specific case. This approach facilitates determination of the pathogenic spectrum, thereby influencing subsequent therapeutic decisions.
The study aims to evaluate the efficacy and diagnostic quality of these chromogenic media for bovine mastitis diagnosis.
MATERIALS AND METHODS
Chromogenic media. Three chromogenic nutrient media were prepared.
Medium I is intended for the determination and differentiation of the most frequently encountered microorganisms of the Enterobacteriaceae family.
Medium II is intended for the determination and differentiation of microorganisms of the genus Staphylococcus.
Medium III is intended for the determination and differentiation of microorganisms of the genus Streptococcus (in particular, S. agalactiae).
For ease of use, the three media were placed in one Petri dish with sectors.
The efficacy of chromogenic nutrient media was determined according to the following criteria: sensitivity, specificity, cultural properties of microorganism control strains, differentiating and inhibitory properties. A commercially available medium, Columbia blood agar (HiMedia Laboratories Pvt Ltd., India) supplemented with 5% defibrinated ram blood served as control.
Control strains. The control strains comprised 22 microbial cultures from the collection of pathogenic and vaccine strains maintained at the Federal Scientific Center VIEV, including: E. coli ATCC 25922, S. agalactiae ATCC 8057, S. aureus ATCC 12600, Klebsiella pneumoniae B-1392, Proteus mirabilis B-1382, Pseudomonas aeruginosa B-1366, Salmonella typhimurium B-1025, Enterococcus faecalis B-1399, Enterococcus faecium 1921, Acinetobacter baumannii 2516, Enterobacter cloacae 1322, Staphylococcus hominis 1377, Staphylococcus equorum 2511, Staphylococcus haemolyticus 2505, Staphylococcus pseudintermedius B-1849, Morganella morganii 1418, Streptococcus uberis 2114, Streptococcus dysgalactiae 2432, Streptococcus pyogenes 1972, Aerococcus viridans 2320, Streptococcus canis 2326, Streptococcus suis 2383.
Preparation of bacterial suspension dilutions. Initial bacterial suspensions were prepared at concentrations of 1×108 to 1×109 CFU/mL using the pharmacopoeial reference standard (PhRS 3.1.00085). To achieve the required seeding densities, serial ten-fold dilutions of the initial suspensions were performed.
Determination of sensitivity. S. agalactiae, S. aureus and E. coli strains were inoculated onto the studied chromogenic and control media in 1 mL at different concentrations: 1 × 100, 1 × 101, 1 × 102 CFU/mL. After (24 ± 2) hours of incubation at 37 °C, the number of grown colonies in all the inoculations was compared. The experiment was performed in triplicate. To compare the mean values of the groups and determine statistically significant differences between them, the Student’s test (t-criterion) was used: the differences are considered statistically significant if p-value < 0.05.
Specificity assessment. Specificity was determined for each chromogenic medium separately. The growth and nature of changes in colonies of different bacterial strains on the same experimental medium were compared and the presence of similarities or differences was noted.
Evaluation of differentiating properties. To determine the differentiating properties, changes in control strains inoculated in chromogenic and control media (structure, color of colonies, color of the medium around the colonies) were compared.
Evaluation of inhibitory properties. Inhibitory properties were determined by the presence or absence of growth of cultures on chromogenic media in comparison with the presence of growth on a control medium.
Testing of media with mastitis milk samples. Eight milk samples (10 mL each) were collected from cows with mastitis confirmed by the Kenotest somatic cell test (CID Lines, Belgium). Samples were collected in sterile biological specimen containers and processed within 2 hours of collection, with storage maintained at +4 to +8 °C. For inoculation, a sterile cotton swab was immersed in each milk sample, excess moisture was removed by touching the container walls, and then streaked in a lawn pattern onto three chromogenic media. The cultures were incubated at 37 °C for 24 hours before result interpretation.
RESULTS AND DISCUSSION
To determine the sensitivity of chromogenic media, three target strains (S. agalactiae, S. aureus, and E. coli) inoculated in 1 mL at three different concentrations (1 × 100, 1 × 101, 1 × 102 CFU/mL) were used. After culturing for 24 hours at 37 °C, the number of colony-forming units for all media was counted. The results are presented in Table 1.
To identify statistically significant differences or similarities, the Student’s t-test was used, the results of which are presented in Table 2.
Based on the obtained data, chromogenic media demonstrate sensitivity comparable to the control medium, as confirmed by statistical analysis (Student’s t-test, p > 0.05). The observed differences between chromogenic media and the control medium showed no statistical significance across all tested strains and concentrations. Thus, these results indicate that chromogenic media effectively support growth of target microorganisms even at minimal inoculum levels.
The specificity, differentiating properties and inhibitory characteristics of the chromogenic media were evaluated concurrently using 22 microbial strains representing diverse species. The results are presented in Table 3.
Medium I was found to be highly specific: most of the tested bacteria formed colonies with unique colors. For example, E. coli formed burgundy colonies, S. aureus – golden, P. aeruginosa – gray-green, and S. equorum – violet-pink. However, some microorganisms, such as E. cloacae and K. pneumoniae, had similar colony colors (violet-blue), which may make it difficult to distinguish them visually. Inhibitory properties were weak: all studied strains of microorganisms demonstrated growth within 24 hours. Nevertheless, medium I ensured effective differentiation of control strains by colony color, which allows visually distinguishing microorganisms already at early stages.
The inhibitory properties of Medium II are pronounced: the growth of most bacteria was absent, with the exception of the target microorganisms – Staphylococcus spp. It is worth noting that the specificity of the medium is low – most staphylococci were stained blue-green. However, the same color was predominantly saprophytic microorganisms, while potentially pathogenic staphylococci (S. aureus and S. haemolyticus) differed in color. For example, S. aureus formed purple colonies, and S. hominis and S. equorum formed blue-green ones, which made it possible to visually distinguish them. Medium II as compared with the control one, provided a differentiation of staphylococci by color.
Medium III demonstrated good inhibitory properties, effectively suppressing the growth of most microorganisms, with the exception of gram-positive cocci and some representatives of the Enterobacteriaceae family. The differentiating and specific properties of the medium were weakly expressed and manifested mainly for enterococci, which were stained blue-green, and for S. agalactiae, which formed blue colonies.
The use of all three chromogenic media in combination provides a comprehensive approach to mastitis diagnosis, demonstrating high sensitivity, specificity and differentiating properties. This method allows for a wide range of microorganisms to be covered, selectively isolating target bacterial groups such as staphylococci, streptococci and enterococci.
For testing in the field, milk samples were collected and then inoculated onto three chromogenic media. The results are shown in the Figure.
The simultaneous use of three media for milk sample inoculation enables nearly species-level differentiation of cultures. In Figure (a) it is evident that Enterococcus sp. grew on Media I and III (supposedly E. faecalis, as E. faecium typically exhibits a darker green coloration). Single colonies on Medium II consist of Staphylococcus sp., while the presence of S. aureus can be ruled out, as it would appear purple on Medium II. Additionally, burgundy colonies on Medium I indicate the presence of E. coli in the sample. In Figure (b), the sample microbiome consists almost exclusively of Enterococcus sp. White and green colonies on Media I and II, respectively, are formed by Staphylococcus sp. microorganisms, excluding S. aureus. Figure (c) reveals a monoculture of Enterococcus sp., most likely E. faecium. The fourth sample shown in Figure (d), contained only filamentous fungi. Another milk sample yielded results similar to (b), while three other cultures showed no growth.
Table 1
Mean colony-forming unit values for each tested microorganism species in experimental and control media
|
CFU/mL |
Medium I |
Medium II |
Medium III |
Control |
|
|
S. agalactiae |
1 × 102 |
116.0 ± 11.4 |
Inhibited |
117.7 ± 12.7 |
105.3 ± 21.4 |
|
1 × 101 |
20.3 ± 1.2 |
21.7 ± 3.8 |
23.0 ± 6.1 |
||
|
1 × 100 |
3.7 ± 1.2 |
5.7 ± 1.5 |
3.3 ± 3.5 |
||
|
S. aureus |
1 × 102 |
112.0 ± 14.0 |
111.3 ± 8.3 |
Inhibited |
118.3 ± 10.0 |
|
1 × 101 |
21.7 ± 3.2 |
17.3 ± 2.1 |
23.0 ± 6.1 |
||
|
1 × 100 |
3.7 ± 2.5 |
4.0 ± 2.6 |
3.0 ± 2.6 |
||
|
E. coli |
1 × 102 |
100.3 ± 4.9 |
Inhibited |
Inhibited |
118.3 ± 9.1 |
|
1 × 101 |
27.0 ± 2.0 |
21.7 ± 1.5 |
|||
|
1 × 100 |
4.3 ± 2.1 |
2.3 ± 2.3 |
|||
Table 2
Statistical significance assessment (Student’s t-test) between compared groups
|
Compared groups |
CFU/mL |
S. agalactiae |
S. aureus |
E. coli |
|
Medium I vs control |
1 × 102 |
0.63 |
0.18 |
0.06 |
|
1 × 101 |
0.45 |
0.81 |
0.12 |
|
|
1 × 100 |
0.89 |
0.42 |
0.18 |
|
|
Medium II vs control |
1 × 102 |
Inhibited |
0.46 |
Inhibited |
|
1 × 101 |
0.30 |
|||
|
1 × 100 |
0.76 |
|||
|
Medium III vs control |
1 × 102 |
0.39 |
Inhibited |
Inhibited |
|
1 × 101 |
0.84 |
|||
|
1 × 100 |
0.48 |
Table 3
Results of tests for specificity, differentiation capacities and inhibitory properties of chromogenic media as compared with control medium
|
Microorganisms |
Medium I |
Medium II |
Medium III |
Control |
||||
|
Growth |
Colony color |
Growth |
Colony color |
Growth |
Colony color |
Growth |
Colony color |
|
|
Escherichia coli |
Good |
Burgundy |
Inhibited |
Inhibited |
Good |
Grayish-white |
||
|
Klebsiella pneumoniae |
Good |
Violet-blue |
Inhibited |
Inhibited |
Good |
Grayish-white |
||
|
Proteus mirabilis |
Good |
Transparent |
Good |
Transparent |
Moderate |
Transparent |
Good |
Grayish-white |
|
Pseudomonas aeruginosa |
Good |
Grey-green |
Inhibited |
Good |
Blue-green |
Good |
Blue-green |
|
|
Salmonella typhimurium |
Good |
Transparent |
Inhibited |
Inhibited |
Good |
Grayish-white |
||
|
Enterococcus faecalis |
Good |
Blue-light blue |
Inhibited |
Good |
Blue-green |
Good |
Grayish-white |
|
|
Enterococcus faecium |
Good |
Blue-green |
Inhibited |
Good |
Blue-green |
Good |
Grayish-white |
|
|
Acinetobacter baumannii |
Good |
Pale-yellow |
Inhibited |
Inhibited |
Good |
Grayish-white |
||
|
Enterobacter cloacae |
Good |
Violet-blue |
Inhibited |
Inhibited |
Good |
Grayish-white |
||
|
Morganella morganii |
Good |
Amber |
Inhibited |
Moderate |
White |
Good |
Grayish-white |
|
|
Staphylococcus aureus |
Good |
Golden |
Moderate |
Violet |
Inhibited |
Good |
Golden |
|
|
Staphylococcus hominis |
Good |
White |
Good |
Blue-green |
Inhibited |
Good |
White |
|
|
Staphylococcus equorum |
Good |
Violet-pink |
Good |
Blue-green |
Inhibited |
Good |
White |
|
|
Staphylococcus haemolyticus |
Good |
White |
Good |
Green |
Inhibited |
Good |
Grayish-white |
|
|
Staphylococcus pseudintermedius |
Good |
Beige-pink |
Good |
Blue-green |
Inhibited |
Good |
Grayish-white |
|
|
Streptococcus agalactiae |
Moderate |
Pale-pink |
Inhibited |
Good |
Blue |
Good |
Grayish-white |
|
|
Streptococcus uberis |
Moderate |
White |
Inhibited |
Moderate |
White |
Good |
Grayish-white |
|
|
Streptococcus dysgalactiae |
Moderate |
Pale-pink |
Inhibited |
Moderate |
White |
Good |
Grayish-white |
|
|
Streptococcus pyogenes |
Moderate |
White |
Inhibited |
Moderate |
White |
Good |
Grayish-white |
|
|
Aerococcus viridans |
Moderate |
White |
Inhibited |
Inhibited |
Good |
Greenish |
||
|
Streptococcus canis |
Moderate |
White |
Inhibited |
Moderate |
White |
Good |
Grayish-white |
|
|
Streptococcus suis |
Moderate |
Pale-pink |
Inhibited |
Moderate |
White |
Good |
Grayish-white |
|
Fig. Testing of culture media using milk samples (cultivated at 37 °C for 24 hours)
CONCLUSION
The developed chromogenic media demonstrate high efficiency in bovine mastitis diagnosis. Medium I, with its high sensitivity and differentiating properties, enables primary screening and detection of a broad spectrum of microorganisms, including members of the Enterobacteriaceae family. Medium II, due to its strong inhibitory properties, selectively isolates staphylococci, which is a critical feature for identifying pathogenic species such as S. aureus. Medium III, while having more limited differentiating capabilities, effectively supports the growth of enterococci and streptococci, including S. agalactiae, making it essential for mastitis diagnosis.
The integrated use of all three media ensures high diagnostic accuracy, enabling not only broad microbial coverage but also selective identification of target bacterial groups. This significantly accelerates pathogen detection and facilitates timely administration of effective therapy. Testing of the media on milk samples from mastitic cows confirmed the media’s practical applicability and effectiveness when used in the field.
During the testing, occasional development of filamentous fungi was observed, which may complicate result interpretation. To address this, further work will focus on optimizing the media composition by evaluating various antifungal preparations at different concentrations. These improvements aim to enhance media specificity by suppressing non-target fungal growth, thereby reducing the risk of false-positive results.
It is worth noting that standardized disposable loops for milk culture make it possible to roughly estimate the number of colony-forming units. While this method lacks high precision, it provides a practical approximation of milk contamination levels, offering valuable preliminary insights into infection severity.
Thus, the developed chromogenic media represent a promising tool for rapid mastitis diagnosis, combining high sensitivity, specificity and differentiating capabilities. Their implementation in veterinary practice could significantly accelerate diagnostic procedures and enhance mastitis treatment efficacy, ultimately improving animal health and dairy herd productivity.
References
1. Zyubin I. N., Smirnov P. N., Naprimerov V. A., Nimatsyrenov G. G. Mastitis in cattle. Novosibirsk: OOO “2D”; 2009. 95 p. (in Russ.)
2. Nikitina M. V., Stolbova O. A., Skosyrskikh L. N. Treatment-and-prophylactic actions at mastitis of cattle. Dairy Farming Journal. 2019; (3): 31–39. https://elibrary.ru/qbdglc (in Russ.)
3. Goulart D. B., Mellata M. Escherichia coli mastitis in dairy cattle: etiology, diagnosis, and treatment challenges. Frontiers in Microbiology. 2022; 13:928346. https://doi.org/10.3389/fmicb.2022.928346
4. Vakkamäki J., Taponen S., Heikkilä A.-M., Pyörälä S. Bacteriological etiology and treatment of mastitis in Finnish dairy herds. Acta Veterinaria Scandinavica. 2017; 59:33. https://doi.org/10.1186/s13028-017-0301-4
5. Oskolkova M. V., Kuzmina E. V. Etiology of mastitis and its interrelation with gynecologic diseases. Izvestia Orenburg State Agrarian University. 2014; (4): 86–88. https://elibrary.ru/sucqyt (in Russ.)
6. Pascu C., Herman V., Iancu I., Costinar L. Etiology of mastitis and antimicrobial resistance in dairy cattle farms in the western part of Romania. Antibiotics. 2022; 11 (1):57. https://doi.org/10.3390/antibiotics11010057
7. Mastitis: etiology, prevention, diagnostic, treatment. Compiled by S. V. Shchepetkina. 2nd ed. supplemented. Saint Petersburg: Saint-Petersburg State Academy of Veterinary Medicine; 2020. 308 p. (in Russ.)
8. Nikitina M. V., Stolbova O. A., Skosyrskikh L. N. Studies on the ethiological factors of cattle mastitis. Izvestia Orenburg State Agrarian University. 2019; (5): 197–200. https://elibrary.ru/vhyltw (in Russ.)
9. Ivanov E. V., Kapustin A. V., Avduevskaya N. N. Study of the vaccination effects against Staphylococcus aureus, causing mastitis and endometritis in cows. Veterinary Science Today. 2024; 13 (4): 360–365. https://doi.org/10.29326/2304-196X-2024-13-4-360-365
10. Ganguly S. Bacteriological examination of cow milk samples collected from case of chronic clinical mastitis. International Journal of Recent Development in Engineering and Technology. 2016; 5 (6): 8–9. https://www.researchgate.net/publication/303994840
11. Lyusin E. A. Criteria for the selection of antibacterial drugs in the treatment of bovine mastitis. Agrarian Science. 2021; 347 (4): 50–52. https://doi.org/10.32634/0869-8155-2021-347-4-50-52 (in Russ.)
12. Ganguly S., Wakchaure R. Bacteriological analysis of cow milk sample suspected of being affected with sub-clinical mastitis. International Journal of Engineering and Innovative Technology. 2016; 6 (3): 38–39. https:// www.researchgate.net/publication/309389480
13. Hoque M. N., Das Z. C., Rahman A. N. M. A., Haider M. G., Islam M. A. Molecular characterization of Staphylococcus aureus strains in bovine mastitis milk in Bangladesh. International Journal of Veterinary Science and Medicine. 2018; 6 (1): 53–60. https://doi.org/10.1016/j.ijvsm.2018.03.008
14. Muzyka V. P., Stetsko T. I., Pashkovskaya M. V., Padovsky V. N. Monitoring chuvstvitel’nosti stafilokokkov k antimikrobnym veshchestvam = Monitoring of Staphylococcus susceptibility to antimicrobials. Transactions of the Educational Establishment “Vitebsk the Order of “the Badge of Honor” State Academy of Veterinary Medicine”. 2012; 48 (2-1): 119–122. https://repo.vsavm.by/handle/123456789/600 (in Russ.)
15. Varenikov M. V., Tashlanov V. V., Morozov I. A. Mastitis prophylaxis leads to high profitability of milk production. Dairy and Beef Cattle Farming. 2014; (8): 32–35. https://elibrary.ru/tecawh (in Russ.)
16. Salat O., Lemaire G., Durel L., Perrot F. Etiology of severe mastitis in French dairy herds. PLoS ONE. 2023; 18 (12):e0295614. https://doi.org/10.1371/journal.pone.0295614
17. Ali T., Kamran, Raziq A., Wazir I., Ullah R., Shah P., et al. Prevalence of mastitis pathogens and antimicrobial susceptibility of isolates from cattle and buffaloes in northwest of Pakistan. Frontiers in Veterinary Science. 2021; 8:746755. https://doi.org/10.3389/fvets.2021.746755
18. Tommasoni C., Fiore E., Lisuzzo A., Gianesella M. Mastitis in dairy cattle: on-farm diagnostics and future perspectives. Animals. 2023; 13 (15):2538. https://doi.org/10.3390/ani13152538
19. Abd El-Tawab A. A., Nabih A. M., Saad W. Bacteriological and molecular diagnosis of most common bacteria causing subclinical mastitis in cow. Benha Veterinary Medical Journal. 2019; 37 (2): 28–32. https://www. researchgate.net/publication/343114382
20. Kahya Demirbilek S., Yıldız M., Akkoç A., Mutlu A. M., Ardıçlı Ö., Aner H. Comparison of bacteriological culture method and multiplex real- time PCR for detection of mastitis. Research in Veterinary Science. 2024; 172:105237. https://doi.org/10.1016/j.rvsc.2024.105237
21. Adkins P. R. F., Middleton J. R. Methods for diagnosing mastitis. Veterinary Clinics of North America: Food Animal Practice. 2018; 34 (3): 479–491. https://doi.org/10.1016/j.cvfa.2018.07.003
22. Chelnokova M. I., Shcherbakova N. A. Cow mastitis diagnostics and treatment. Proceedings of the State Agricultural Academy of Velikie Luki. 2018; (1): 20–24. https://elibrary.ru/uqrcaa (in Russ.)
23. Chernenok V. V., Hotmirova O. V., Chernenok Yu. N. Methods of diagnostics and treatment of mastitis in cows. Vestnik Kurskoj gosudarstvennoj sel’skohozyajstvennoj akademii. 2020; (4): 40–43. https://elibrary.ru/ygwehu (in Russ.)
24. Shleinikova A. A., Skubko O. R. Diagnosis of mastitis in cattle. Nauchno-innovatsionnoe razvitie veterinarnoi nauki i praktiki: materialy Natsional’noi (Vserossiiskoi) nauchnoprakticheskoi konferentsii (Omsk, 10 noyabrya 2022 g.) = Scientific and Innovative Development of Veterinary Science and Practice: proceedings of the National (AllRussian) ScientificPractical Conference (Omsk, November 10, 2022). Omsk: Omsk State Agrarian University; 2022; 77–80. https://www.elibrary.ru/gmiyot (in Russ.)
25. Ganguly S., Para P. A., Praveen P. K. Bacteriological examination of cow milk samples suspected of clinical mastitis: a case study. International Journal of Pure & Applied Bioscience. 2017; 5 (1): 207–209. https://doi.org/10.18782/2320-7051.2518
26. Ladanova M. A. Mastitis in cattle. Aktual’nye voprosy veterinarnoi meditsiny: materialy mezhdunarodnoi nauchnoi konferentsii, posvyashchennoi 100letiyu kafedr klinicheskoi diagnostiki, vnutrennikh boleznei zhivotnykh im. Sineva A. V., akusherstva i operativnoi khirurgii (Sankt Peterburg, 29–30 sentyabrya 2022 g.) = Current issues in veterinary medicine: Proceedings of the International Scientific Conference dedicated to the 100th anniversary of the Departments of Clinical Diagnosis, Animal Internal Disea ses named after A. V. Sinev, Obstetrics and Operative Surgery (Saint Petersburg, September 29–30, 2022). Saint Petersburg: Saint-Petersburg State University of Veterinary Medicine; 2022; 75–79. https://doi.org/10.52419/3006-2022-5 (in Russ.)
27. Ganguly S., Padhy A., Sahoo S., Garg Sh. L., Praveen P. K., Wakchaure R. Bacteriological examination and antibiogram of milk sample of clinically infected dairy cow suffering from mastitis. International Journal of Medical Microbiology and Tropical Diseases. 2015; 1 (1): 6–7. https://www.researchgate.net/publication/290427340
28. Jangulova A. N., Kukhar Ye. V., Akanova Zh. Zh., Kurmanov B. A. Application of compact dry tests in the field. Fundamental’nye i prikladnye nauchnye issledovaniya: aktual’nye voprosy, dostizheniya i innovatsii: sbornik statei XLVII Mezhdunarodnoi nauchno-prakticheskoi konferentsii (Penza, 30 iyulya 2021 g.) = Fundamental and applied scientific research: currentissues, achievements and innovations: collection of papers of the XLVII International Scientific and Practical Conference (Penza, July 30, 2021). Penza: International Centerfor Scientific Cooperation “Science and Enlightenment”; 2021; 63–70. https://elibrary.ru/unssnp (in Russ.)
29. Galkin A. V., Solovyeva O. I., Kalashnikova G. T., Elagina A. A. Diagnostika vozbuditelei mastita u korov s pomoshch’yu podlozhek RIDA® COUNT = Diagnosis of mastitis pathogens using RIDA® COUNT plates. Molochnaya reka. 2012; (4): 44–45. https://elibrary.ru/egtmiu (in Russ.)
About the Authors
A. V. KapustinRussian Federation
Andrey V. Kapustin, Dr. Sci. (Biology), Associate Professor, First Deputy Director,
24/1, Ryazansky prospekt, Moscow 109428.
A. I. Laishevtsev
Russian Federation
Aleksey I. Laishevtsev, Cand. Sci. (Biology), Leading Researcher, Acting Head, Laboratory for Diagnostics and Control of Antibiotic Resistance of Pathogens of the Most Clinically Significant Infectious Animal Diseases,
24/1, Ryazansky prospekt, Moscow 109428.
V. A. Savinov
Russian Federation
Vasiliy A. Savinov, Cand. Sci. (Biology), Senior Researcher, Laboratories of Mycology and Antibiotics named after A. H. Sarkisov,
24/1, Ryazansky prospekt, Moscow 109428.
P. N. Shastin
Russian Federation
Pavel N. Shastin, Cand. Sci. (Veterinary Medicine), Senior Researcher, Laboratory for Diagnostics and Control of Antibiotic Resistance of Pathogens of the Most Clinically Significant Infectious Animal Diseases,
24/1, Ryazansky prospekt, Moscow 109428.
Kh. Kh. Gilmanov
Russian Federation
Khamid Kh. Gilmanov, Cand. Sci. (Biology), Senior Researcher, Laboratory of Leukemia,
24/1, Ryazansky prospekt, Moscow 109428.
A. V. Khabarova
Russian Federation
Alla V. Khabarova, Junior Researcher, Laboratory for Diagnostics and Control of Antibiotic Resistance of Pathogens of the Most Clinically Significant Infectious Animal Diseases,
24/1, Ryazansky prospekt, Moscow 109428.
Review
For citations:
Kapustin A.V., Laishevtsev A.I., Savinov V.A., Shastin P.N., Gilmanov Kh.Kh., Khabarova A.V. Development and testing of a set of chromogenic media for rapid diagnosis of bovine mastitis. Veterinary Science Today. 2025;14(2):171-178. https://doi.org/10.29326/2304-196X-2025-14-2-171-178
JATS XML



























